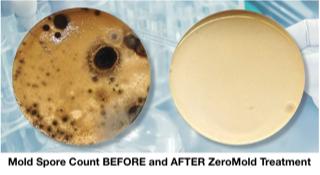
ZeroMold

Collins Bowen & Associates Inc
Closed
154 E 14075 S
Draper, UT 84020
Collins Bowen & Associates Inc in Draper is dedicated to showcasing their latest projects, news, and events, emphasizing their commitment to fostering a respectful working environment that values and develops employees of diverse backgrounds, perspectives, and experiences.
As a Utah and Idaho engineering firm, Bowen Collins Associates, Inc. provides professional services while prioritizing inclusivity and diversity in their workforce, ensuring a well-rounded and innovative approach to their projects.
Generated from their website's infomation
See a problem?
You might also like
Partial Data by Infogroup (c) 2024. All rights reserved.